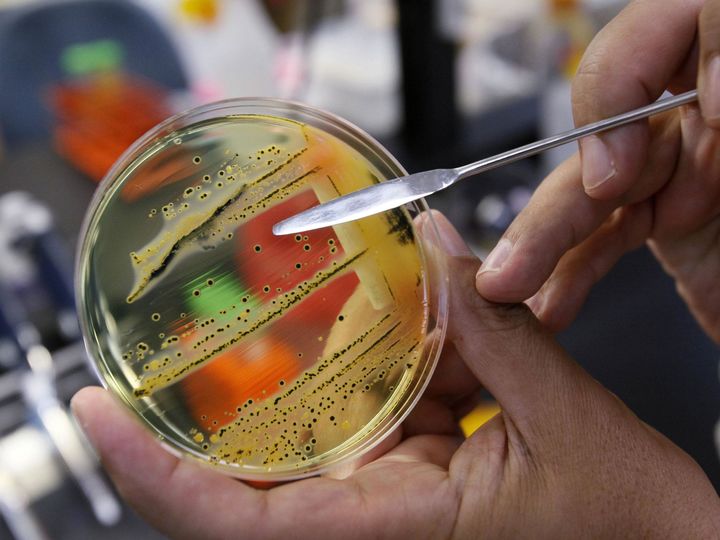

G‘arbiy Nil bezgagi Moskvagacha yetib keldi
Nil bezgagi uchun tabiiy rezervuar yovvoyi qushlar hisoblanadi. Qishda ular issiq mamlakatlarga uchib ketadi. U yerda viruslar bilan kasallanib, yana odatdagi joyiga qaytib keladi (MA» 2021 yil 36-son).
«Rossiyada kasallikning tabiiy o‘chog‘i taxminan 1999 yildan mamlakat janubi – Qalmiqiston, Astraxan, Rostov oblastida paydo bo‘ldi. Krasnodar va Stavropol o‘lkalarida hamda boshqa hududlarga ham yoyilmoqda. Yaqinda poytaxt ornitologlarini laboratoriya tadqiqotlari natijalari hayratda qoldirdi. Moskvada qarg‘alar o‘liklarida G‘arbiy Nil bezgagi virusi aniqlandi.
G‘arbiy Nil bezgagi – isitma virusi 1937 yilda O‘gandada kasal ayol qonida aniqlangandi. Kasallik odatda tumovga o‘xshash belgilar bilan paydo bo‘lib, unchalik sezilmaydi. Ammo virus talvasaga tushishga yoki miningitga olib kelishi, agar vaqtida shifokorga murojaat qilinmasa, o‘lim bilan tugashi mumkin. Rossiyadagidek manzara Yevropada ham kuzatilmoqda. Olimlarning prognozlari bo‘yicha kasallik 2050 yilga borib Shvetsiyaga tarqalishi mumkin.
T.ShOMURODOV tayyorladi.